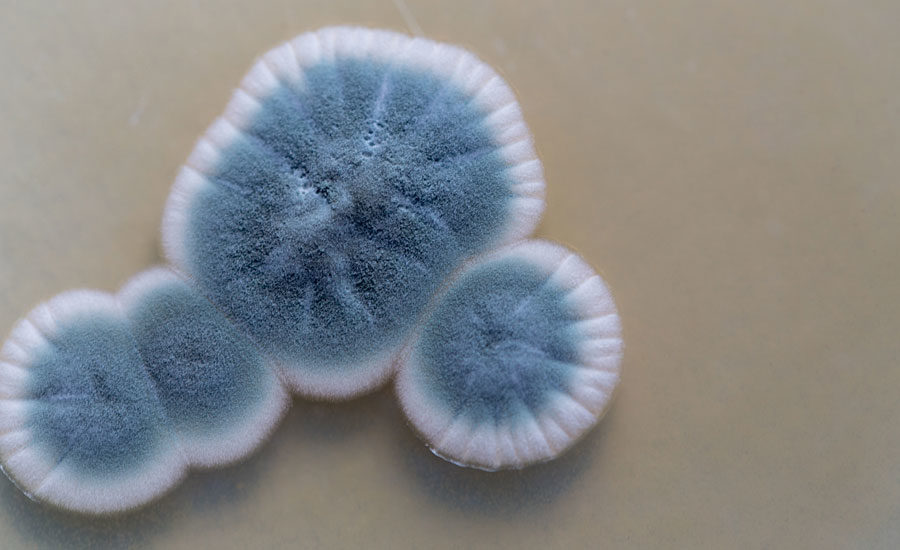

Danh mục sản phẩm
- Sơn và Mực in
- Chất tạo màng
- Hoàn thiện bề mặt kim loại
- Polymer
- Phụ gia thực phẩm
- Hóa dầu
- Thiết bị
- Trang thiết bị y tế
-
Viên gỗ nén
Tìm kiếm sản phẩm
Sơn & Mực in
Giải Mã Sự Phát Triển Của Vi Sinh Vật Trong Sơn: Hậu Quả và Giải Pháp

A. Ảnh Hưởng của Vi Sinh Vật Đối Với Nhũ Tương Polyme
1. Làm Giảm Độ Bền của Màng Sơn
1.1 Enzyme Phân Hủy Chất Kết Dính
Vi sinh vật, bao gồm cả vi khuẩn và nấm mốc, có khả năng tiết ra enzyme phân hủy chất kết dính trong sơn. Nhũ tương polyme trong sơn hoạt động như một chất kết dính, giữ các thành phần của sơn liên kết với nhau. Khi bị enzyme của vi sinh vật phân hủy, lớp kết dính này trở nên yếu đi, dẫn đến màng sơn bị giòn và dễ bong tróc. Điều này không chỉ làm giảm tuổi thọ của lớp sơn mà còn gây mất thẩm mỹ cho bề mặt được sơn.
1.2 Axit Làm Hỏng Bề Mặt
Một số vi sinh vật có thể tạo ra các axit trong quá trình phát triển của chúng. Những axit này có thể ăn mòn và làm hỏng bề mặt vật liệu, đặc biệt là kim loại. Khi axit tiếp xúc với bề mặt được sơn, chúng gây ra sự ăn mòn và rỉ sét, dẫn đến bong tróc sơn và làm giảm độ bền của lớp sơn.
2. Gây Ố Vàng và Nấm Mốc
2.1 Phát Triển của Nấm Mốc
Nấm mốc là một loại vi sinh vật thường xuyên xuất hiện trên bề mặt sơn, đặc biệt là trong môi trường ẩm ướt. Nấm mốc không chỉ gây ra các đốm ố vàng trên bề mặt sơn mà còn tạo ra mảng bám mất thẩm mỹ. Điều này không chỉ ảnh hưởng đến vẻ đẹp của công trình mà còn gây ra các vấn đề về sức khỏe.
2.2 Ảnh Hưởng Đến Sức Khỏe
Nấm mốc có thể phát tán bào tử vào không khí, gây ra các vấn đề hô hấp cho con người, đặc biệt là những người bị dị ứng hoặc hen suyễn. Sự hiện diện của nấm mốc trên bề mặt sơn có thể làm tăng nguy cơ tiếp xúc với các chất gây dị ứng, ảnh hưởng nghiêm trọng đến sức khỏe.
3. Mùi Hôi
Một số loại vi sinh vật có khả năng tạo ra các hợp chất gây mùi khó chịu. Khi vi sinh vật phát triển trong sơn, chúng có thể tiết ra những hợp chất này, gây ra mùi hôi ảnh hưởng đến không gian sống. Mùi hôi không chỉ gây khó chịu mà còn là dấu hiệu của sự phát triển vi sinh vật, cho thấy sự xuống cấp của chất lượng sơn.
4. Gây Ra Các Vấn Đề Về An Toàn
4.1 Nguy Cơ Gây Bệnh
Một số vi sinh vật có thể gây bệnh cho con người, đặc biệt là trong môi trường ẩm ướt và kín. Các loại vi khuẩn và nấm có thể phát triển mạnh mẽ trong những điều kiện này, tăng nguy cơ nhiễm bệnh và gây ra các vấn đề sức khỏe nghiêm trọng.
4.2 Sự An Toàn Của Công Trình
Sự phát triển của vi sinh vật trong sơn cũng có thể ảnh hưởng đến cấu trúc và sự an toàn của công trình. Các axit và enzyme mà vi sinh vật tiết ra có thể làm suy yếu các vật liệu xây dựng, gây ra các vấn đề về an toàn.
B. Các Biện Pháp Phòng Ngừa Sự Phát Triển của Vi Sinh Vật Trong Sơn
1. Sử Dụng Sơn Có Chất Chống Nấm Mốc
Nhiều loại sơn hiện nay được bổ sung các chất chống nấm mốc giúp ức chế sự phát triển của vi sinh vật. Việc sử dụng sơn có chứa các chất này là một cách hiệu quả để bảo vệ bề mặt khỏi sự tấn công của vi sinh vật. Đặc biệt là trong những khu vực có độ ẩm cao, việc lựa chọn sơn chống nấm mốc là vô cùng quan trọng.

2. Bảo Quản Sơn Ở Nơi Khô Ráo, Thoáng Mát
Vi sinh vật phát triển mạnh trong môi trường ẩm ướt. Để ngăn ngừa sự phát triển của chúng, cần bảo quản sơn ở nơi khô ráo, thoáng mát và tránh xa nguồn nước. Điều này không chỉ giúp bảo vệ chất lượng sơn mà còn kéo dài thời gian bảo quản của sản phẩm.
3. Làm Sạch Bề Mặt Trước Khi Sơn
Trước khi thi công sơn, bề mặt cần phải được làm sạch bụi bẩn, dầu mỡ và nấm mốc. Điều này giúp tạo ra một bề mặt sạch, tăng độ bám dính của sơn và ngăn ngừa vi sinh vật phát triển trên bề mặt sơn sau này. Việc làm sạch bề mặt trước khi sơn cũng giúp lớp sơn đều màu và đẹp hơn.
4. Đảm Bảo Bề Mặt Sơn Khô Hoàn Toàn
Sau khi thi công sơn, cần đảm bảo bề mặt khô hoàn toàn để ngăn ngừa sự phát triển của vi sinh vật. Bề mặt ẩm ướt là điều kiện lý tưởng cho vi sinh vật phát triển, do đó việc kiểm tra và đảm bảo bề mặt khô ráo là rất quan trọng.
5. Sử Dụng Các Biện Pháp Kiểm Soát Độ Ẩm
Độ ẩm cao trong nhà có thể tạo điều kiện cho vi sinh vật phát triển. Để kiểm soát độ ẩm, có thể sử dụng máy hút ẩm hoặc quạt thông gió. Những biện pháp này giúp duy trì mức độ ẩm thích hợp trong không gian sống, ngăn ngừa sự phát triển của vi sinh vật.
6. Lựa Chọn Loại Sơn Phù Hợp
Việc lựa chọn loại sơn phù hợp với môi trường sử dụng cũng rất quan trọng. Ví dụ, đối với những khu vực ẩm ướt như phòng tắm hoặc nhà bếp, nên sử dụng loại sơn có khả năng chống ẩm cao. Điều này giúp bảo vệ bề mặt sơn khỏi sự tấn công của vi sinh vật và kéo dài tuổi thọ của lớp sơn.
Kết Luận
Sự phát triển của vi sinh vật trong sơn có thể gây ra nhiều vấn đề nghiêm trọng, ảnh hưởng đến cả chất lượng và thẩm mỹ của lớp sơn. Tuy nhiên, bằng cách áp dụng các biện pháp phòng ngừa như sử dụng sơn chống nấm mốc, bảo quản sơn đúng cách, và kiểm soát độ ẩm, chúng ta có thể hạn chế tối đa những ảnh hưởng này. Lựa chọn loại sơn phù hợp với môi trường sử dụng cũng là một yếu tố quan trọng để bảo vệ lớp sơn và duy trì vẻ đẹp của công trình.
Việc hiểu rõ và phòng ngừa sự phát triển của vi sinh vật trong sơn không chỉ giúp bảo vệ tài sản của bạn mà còn đảm bảo an toàn và sức khỏe cho không gian sống của gia đình bạn.


